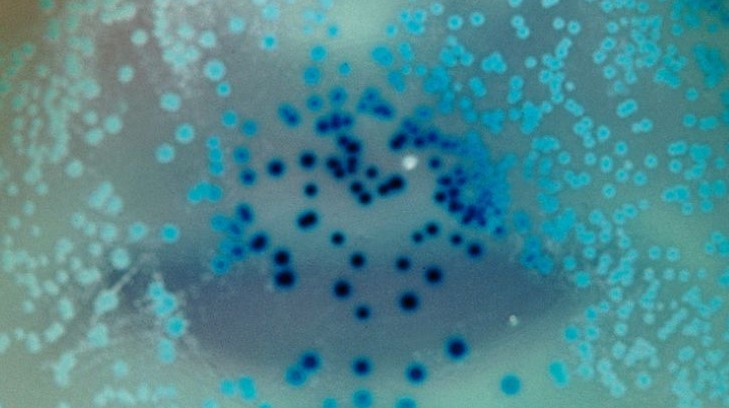

Иначе эта гангрена останется потомкам: Ищенко ответил, как России нужно закончить СВО
Теоретически возможны разные варианты окончания СВО, включая сохранение Украины как дружественного России государства. Однако на практике это невозможно, "потому что есть конкретные люди, есть их конкретные интересы, конкретные взгляды" ukraina.ru »